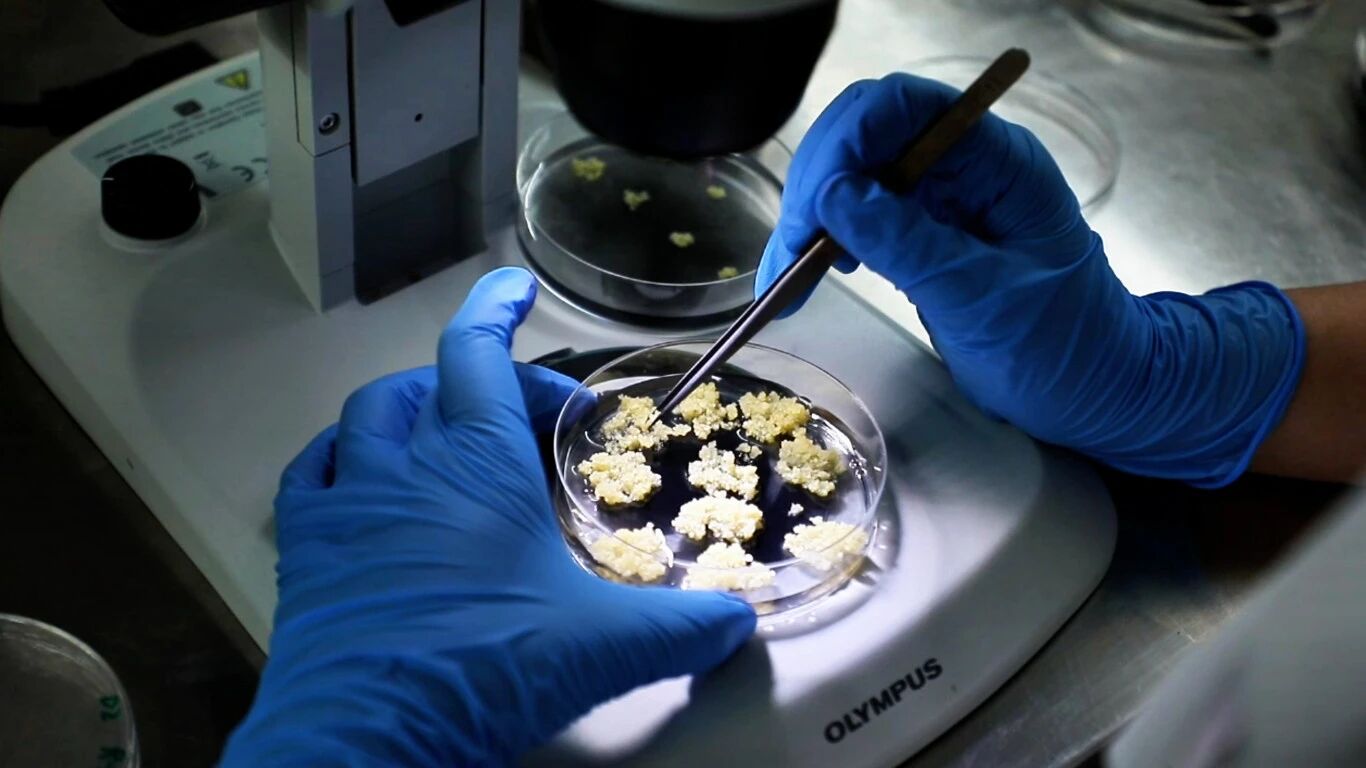

科技赋能高原农业:从实验室到田间的种源振兴之路
清晨,薄雾如纱般笼罩着昆明市盘龙区松华街道高原植物种质保护繁育基地(以下简称高繁基地),湿润的空气中弥漫着泥土与草木的清香。作为承载高原植物种质保护与繁育的重要平台,这片土地正以独特的生态优势与创新实践,书写着种源守护与乡村振兴的双向答卷。


松华街道位于低纬高原地区,独特的海拔、优质的水源和湿润的气候,让这里成为珍稀植物种质资源的“天然宝库”。近年来,依托中国科学院昆明植物研究所的科研力量和丰富的种质资源,松华街道与盘龙区农投公司、昆明植物研究所共同开启了一场为期30年的“种子芯片”守护计划,为高原植物种质资源的保护与创新利用按下“启动键”。

提及咖啡育种,人们总会想到“十年磨一剑”的漫长等待,而如今,这一过程被体细胞胚育种技术按下了“加速键”。实验室里,中国科学院昆明植物研究所 中国西南野生生物种质资源库林亮博士熟练地操作着仪器,勾勒出科技赋能的生动图景。“体细胞胚育种技术不仅大幅缩短了咖啡育种的周期,还能快速推广新品种和优良品种,促进云南咖啡产业向精品化转型。”林亮表示,这一技术的应用,对推动咖啡产业高质量发展具有重要意义,也让科技赋能从抽象的概念转化为看得见的现实改变。

如果说咖啡育种是“科技竞速”,那豆类培育便是高原上的“优生选拔”。在高繁基地的试验田里,技术人员仔细观察、记录着自然环境下不同品种大豆的性状和生长态势。“我们希望通过实验,探究大豆适应不同海拔的原因,并通过多种途径挖掘不同品种大豆在高海拔环境中的适应机制,找到适合高海拔种植的优良基因,进而将其应用到大豆育种中去。”中国科学院昆明植物研究所喻辉辉博士解释道,高原环境独特的气候条件对作物生长既是机遇也是挑战,通过推广“优等生”品种,让更优质的大豆品种在高原扎根,为高原农业的可持续发展提供坚实的种源支撑。


基地选址昆明市盘龙区松华街道绝非偶然,其建设意义也远不止收集和保存生物资源。“选择在松华街道建设基地,主要是基于其区位、科技和人才、生态三大核心优势。”中国科学院昆明植物研究所 中国西南野生生物种质资源库副主任于富强博士表示,该基地的建设能充分发挥茨坝片区科技资源优势,为科研人员开展种质研发提供绝佳场所。同时,针对种质资源库内生物资源在保存过程中出现的退化问题,该基地还承担着种质复壮、资源挖掘利用两大职能,从种质收集保存到活性保持再到创新应用,形成了一套完整的种质资源保障链条。

科研的成果,最终要落到田间、真正惠及农民。据盘龙区农投公司副总经理罗文介绍,基地建设的目标是吸引科研单位、种业企业集聚于此,打造一个集品种研发、繁育复壮、科技成果转化及推广示范于一体的综合平台。目前,基地已通过与村集体、合作社及种业企业合作,带动当地部分农户就近就业,有效提升了村集体与农户的收入。“除持续推进国家级种子创新基地建设外,我们还计划打造绿色循环、零排放的基地,使其成为具有代表性的都市农业综合示范基地。”于富强对基地未来的发展充满信心,期待未来为农业绿色高质量发展提供更多可复制、可推广的实践经验。


如今的高繁基地,既是“种子芯片”的守护站,也是乡村振兴的“动力源”,让科研成果转化为助农增收的实用技术,实现科研价值、产业效益与农户利益的同频共振。








